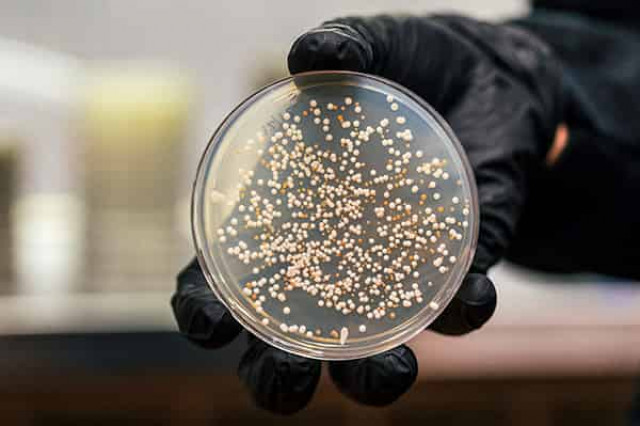
Оно живое!

Уряд РФ готується до падіння експорту нафти до Індії на 30% та дефіциту бюджету
Уряд РФ готується до падіння експорту нафти до Індії на 30% та дефіциту бюджету
 Саміт на Алясці став "великою аферою" Путіна, - WSJ
Саміт на Алясці став "великою аферою" Путіна, - WSJ
 Моді відмовився зупинити імпорт російської нафти, - Bloomberg
Моді відмовився зупинити імпорт російської нафти, - Bloomberg
 Індія зухвало відмовила Трампу, нагадавши про торгівлю США і РФ
Індія зухвало відмовила Трампу, нагадавши про торгівлю США і РФ
 "Дедлайн" Трампа для Кремля може пройти тихо і без наслідків, - AP
"Дедлайн" Трампа для Кремля може пройти тихо і без наслідків, - AP
 Збільшення видобутку ОПЕК+ та нові погрози Трампа тиснуть на ціни на нафту
Збільшення видобутку ОПЕК+ та нові погрози Трампа тиснуть на ціни на нафту
 На лінії фронту в Україні зона ураження стає дедалі глибшою: в The Economist назвали причини
На лінії фронту в Україні зона ураження стає дедалі глибшою: в The Economist назвали причини
 У російському Брянську пролунали потужні вибухи в районі аеропорту
У російському Брянську пролунали потужні вибухи в районі аеропорту
 Трампу імпічмент, Венсу – посаду: Маск продовжує підливати масла у вогонь
Трампу імпічмент, Венсу – посаду: Маск продовжує підливати масла у вогонь
 Росія масовано атакувала Україну дронами і ракетами: є руйнування і постраждалі
Росія масовано атакувала Україну дронами і ракетами: є руйнування і постраждалі
 Нічний удар Росії по Україні: жителі деяких міст залишилися без світла
Нічний удар Росії по Україні: жителі деяких міст залишилися без світла
 Росія планує у 2026 році захопити дві області та відрізати Україну від Чорного моря, - ОП
Росія планує у 2026 році захопити дві області та відрізати Україну від Чорного моря, - ОП
 У США закликали видворити Маска з країни після сварки з Трампом, - The Hill
У США закликали видворити Маска з країни після сварки з Трампом, - The Hill
 Низка поїздів спізнюється через наслідки атаки на Київ
Низка поїздів спізнюється через наслідки атаки на Київ
 Під час нічного удару росіян у Києві загинули рятувальники
Під час нічного удару росіян у Києві загинули рятувальники
 Порошенко залишив собі слона і причіп, а всі дохідні активи намагався переписати на дружину, - ЗМІ
Порошенко залишив собі слона і причіп, а всі дохідні активи намагався переписати на дружину, - ЗМІ
 В Україні з'явиться військовий омбудсмен: Рада зробила перший крок
В Україні з'явиться військовий омбудсмен: Рада зробила перший крок
 Унікальна спецоперація: СБУ втретє вразила Кримський міст
Унікальна спецоперація: СБУ втретє вразила Кримський міст
 Британія готова судитися з Абрамовичем, щоб передати Україні гроші із продажу "Челсі"
Британія готова судитися з Абрамовичем, щоб передати Україні гроші із продажу "Челсі"
 Ключовий союзник Трампа підтримав законопроект про пекельні санкції проти РФ
Ключовий союзник Трампа підтримав законопроект про пекельні санкції проти РФ
 Росіяни зберігають можливості для масованих авіаударів, але тепер вони обмежені, - експерт
Росіяни зберігають можливості для масованих авіаударів, але тепер вони обмежені, - експерт
 Олена Тополя відверто зізналася, що робила пластику грудей
Олена Тополя відверто зізналася, що робила пластику грудей
 Як рясні дощі вплинуть на врожай картоплі в Україні: відповідь фермера
Як рясні дощі вплинуть на врожай картоплі в Україні: відповідь фермера
 "Це не просто епізод": Шмигаль заявив, що "Павутина" може повторитись
"Це не просто епізод": Шмигаль заявив, що "Павутина" може повторитись
 Генштаб відзвітував про знищення 12 російських літаків
Генштаб відзвітував про знищення 12 російських літаків
В США создали синтетическую форму жизни
Американские ученые получили дрожжи, треть генома которых — искусственная. В рамках проекта по созданию синтетического организма биологи изготовили пять усовершенствованных хромосом, из которых была выброшена нестабильная и ненужная для жизнедеятельности клеток ДНК.
24 апреля 1996 года ученые сообщили в журнале Science, что им удалось впервые секвенировать геном эукариотических организмов — дрожжей Saccharomyces cerevisiae. Вся ДНК этих одноклеточных грибов содержится в 16 хромосомах и в совокупности состоит из 12 миллионов пар оснований. На это потребовалось 12 лет и усилия сотни лабораторий.
В 2000-х годах в науке возникло новое направление — синтетическая биология. Исследователи, работающие в этой сфере, создают в лабораториях различные системы из белков и нуклеиновых кислот, чтобы в конечном итоге получить искусственный организм. Один из разделов синтетической биологии — синтетическая геномика, посвященная попыткам заново собрать геномы, которые послужат основой для будущих живых «синтетиков».
Природа ошибается
В 2011 году американские ученые из Университета Джонса Хопкинса под руководством Джефа Боке (Jef Boeke) запустили проект по созданию синтетического генома (Synthetic Yeast Genome Project). Его цель — получение новой версии генома пекарских дрожжей Saccharomyces cerevisiae — Sc2.0. Почему именно дрожжей? Не только потому, что у этих эукариотов сравнительно маленький геном. Важно, что S.cerevisiae — один из самых изученных организмов на планете, и ученым известно, какие функции выполняют те или иные гены в клетках. Эти знания необходимы для того, чтобы построить «улучшенный» геном дрожжей.
На самом деле геномы эукариотов далеки от идеала. Мало того что ДНК подвержена таким мутациям, как вставки и выпадения (делеции) нуклеотидов, удвоения участков или изменения структуры хромосом. В ней также могут присутствовать неработающие гены (псевдогены) и мобильные генетические элементы (ретротранспозоны), способные самовоспроизводиться и распространяться по всему геному.
Конечно, изменения в ДНК приводят к возникновению новых свойств и признаков у организмов, однако эволюция, двигателем которой служат случайные процессы, не следует принципам экономии и эффективности. В результате большая часть генома эукариотов состоит из ДНК, которая либо «мертва», либо занимается бесполезным для клетки самокопированием. Кроме того, из-за большого количества повторяющихся последовательностей геном теряет в стабильности, что делает его более подверженным мутациям. В отличие от природы, ученые могут целенаправленно перестраивать геномы так, чтобы оставалась только необходимая для жизнедеятельности ДНК.
Версия 2.0
В новой работе в рамках проекта Sc2.0 ученые синтезировали несколько хромосом S.cerevisiae, убрав из них все транспозоны, повторяющиеся последовательности ДНК и множество интронов — некодирующих белки участков гена. Более того, они перекодировали кодоны TAG — короткие фрагменты ДНК, состоящие из трех нуклеотидов (T, A и G). Дело в том, что в процессе транскрипции, когда на основе гена синтезируется матричная РНК (мРНК), TAG-кодоны конвертируются в UAG-кодоны (T заменяется на U). При синтезе белка мРНК проходит через рибосомы, а UAG служит стоп-сигналом, прерывающим процесс. Исследователи изменили TAG на TAA, который конвертируется в другой стоп-кодон — UAA.
Какой в этом смысл? Всего существует три стоп-кодона — UAG, UAA, и UGA. Однако процесс синтеза белка не прервется без наличия одного из двух белков, называемых факторами терминации трансляции, — RF1 и RF2. При этом RF1 «обслуживает» кодоны UAA и UAG, а RF2 — UAA и UGA. Если превратить все UAG в UAA, клетка уже не будет зависеть от RF1.
Еще одна модификация касается транспортных РНК (тРНК). Эти молекулы участвуют в синтезе белков и подобно грузовикам «подвозят» необходимые аминокислоты к растущей полипептидной цепи. Последовательности тРНК закодированы в генах, расположенных на разных хромосомах. Ученые переместили гены со своих мест в специально созданную хромосому, кодирующую только тРНК.
Природные хромосомы на искусственные очень трудно заменить в один шаг. Ученые воспользовались процессом гомологичной рекомбинации, когда происходит обмен фрагментами между похожими ДНК. Шаг за шагом исследователи заменяли участки хромосом длиной в 30-60 тысяч нуклеотидов. Разными хромосомами занимались разные лаборатории. В конце концов были получены отдельные штаммы дрожжей, в каждом из которых была заменена одна из хромосом. Для их объединения в одном организме штаммы скрещивали друг с другом.
Таким образом удалось создать дрожжи, чей геном на одну треть является синтетическим. По оценкам авторов работы, всего на проект Sc2.0 может быть потрачено более миллиона долларов.
Для чего это надо
Ученые, занимающиеся синтетической геномикой, преследуют две цели. Во-первых, подробнее изучить функции хромосом, значение организации генома, других процессов, связанных с ДНК, а также влияние эволюционных процессов.
Во-вторых, исследования в этой области позволят создавать организмы с нужными свойствами. Например, ученые могут получить сообщества искусственных бактерий-биофабрик, производящих биотопливо или новые антибиотики. Последнее особенно актуально, поскольку в мире все большее распространение получают микроорганизмы, устойчивые к антибактериальным препаратам. Кроме того, синтетические существа способны выживать в таких экстремальных условиях, как шахтные воды, очищая их от тяжелых металлов и других загрязняющих веществ.